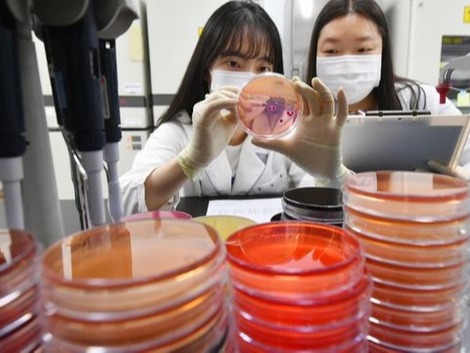
▲경기 수원시 권선구 경기도보건환경연구원에서 연구원들이 식중독균 배양분리작업을 하고 있다. 사진=뉴시스

김시온 기자
artistxion@todaykorea.co.kr
기자페이지
오유경 식약처장은 18일 대구광역시 달성군에 위치한 광주 방면 논공고속도로 휴게소를 찾아 추석 명절 고속도로 휴게소 방문 시 올바른 음식 구입과 보관 요령을 안내했다.
오 처장은 “가을철에는 아침과 저녁은 쌀쌀하지만 낮에는 기온이 상승하므로 귀성길과 성묫길에는 음식을 상온에 오래 보관하지 말고 빨리 섭취해야 한다”고 말했다.
또한 귀성길 휴게소에서 음식을 구매해 장시간 보관하려면 가급적 보냉 가방과 아이스백 등을 이용해 보관해야 하고, 섭취 시 재가열이 권장된다.
아울러 음식점 이용 시 해썹(HACCP) 인증 유무를 확인하고, 전문 도시락제업체 등의 제품을 구입하는 것이 안전하다.
앞서 식약처는 지난 11일 가을철 식중독 발생 건수가 여름 다음으로 많다고 밝히면서 예방에 힘쓸 것을 당부했다.
당시 식약처는 가을철 일교차가 커지는 시기 식중독 발생이 증가한다고 안내했다.
한편, 식중독 사고는 최근 연이어 발생하고 있다.
최근 제주도의 한 식당에서 회 코스를 먹은 일행이 집단 식중독 의심증세를 보여 보건당국이 역학조사에 나섰다.
당국에 따르면 이날 서귀포시 한 리조트에서 숙박하던 15명이 구역질과 복통을 호소하는 등 식중독 의심 증세를 보여 병원으로 이송됐다.
이들은 전날(17일) 오후 6시께 제주시 한 식당에서 회 코스를 먹은 뒤 증상을 호소한 것으로 파악된다.
지난 5일에도 진주시의 한 중학교에서 급식을 먹은 학생 7명이 설사와 발열, 구토 등 증상을 보인다는 신고가 접수됐고, 이달 초에는 기독교복음선교회(JMS)가 개최한 수련회에서 집단 식중독이 발생하면서 다수의 신도가 병원 치료받았다.

